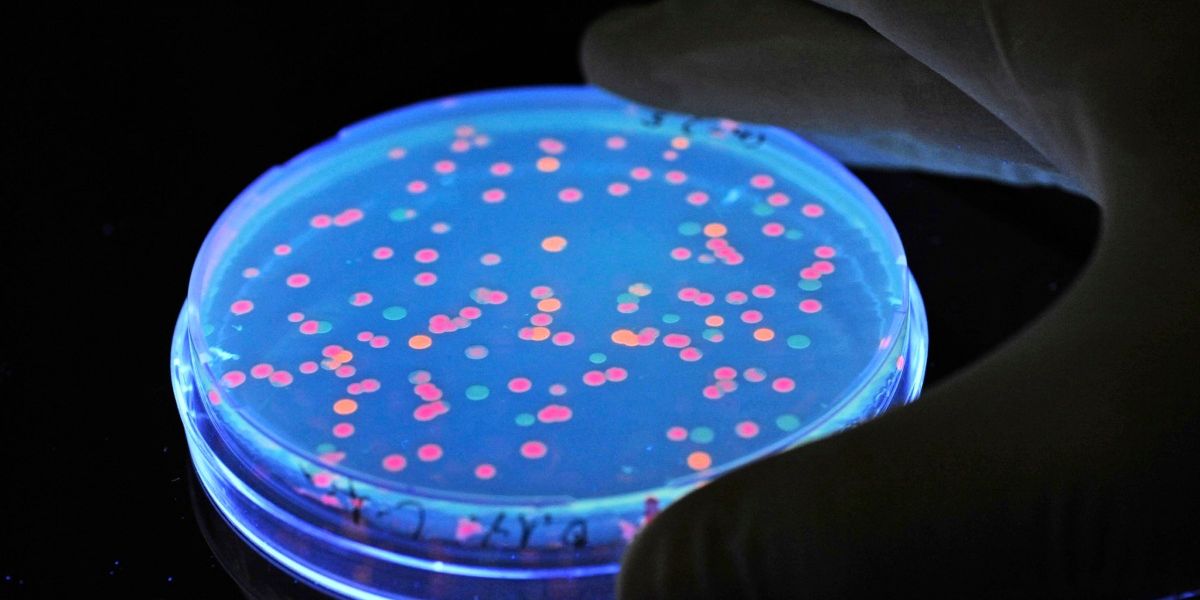

The diverse consequences of the pandemic are still being felt in a wide variety of areas in Austria. In addition to the economic effects, the loss of trust in science is a much-discussed topic. As the latest survey data from Austria shows, at least this burden of the pandemic appears to have now been overcome. “After the long Covid period, trust in science is back,” said Heinz Faßmann, President of the Austrian Academy of Sciences (ÖAW) at the presentation of the science barometer on Friday in Vienna.